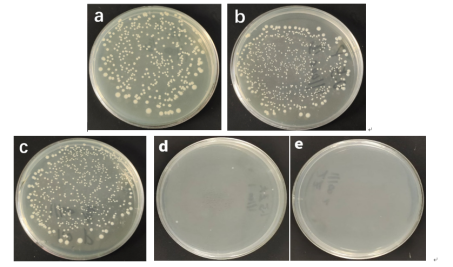

近日,杏吧原创
潘莉莎教授团队在国际知名期刊《International Journal of Biological Macromolecules》(IF=7.7,中科院1区TOP)上公开发表题为“Continuous preparation and antibacterial mechanisms of biodegradable polylactic acid/nano-zinc oxide/additives antibacterial non-wovens”的研究论文。
无纺布是指由化学纤维材料粘合制备而成的外观与功能接近织布的纺织品,具有制备方便,透气性好等一系列优点,在土工布、购物袋、口罩、防护服和医用辅料等有着广泛的应用。目前,无纺布的主要原料为不可降解的聚丙烯和聚酯,其废弃后若焚烧将产生有害气体,掩埋或抛弃到土壤中难以被微生物降解,给环境保护带来了巨大的压力。
聚乳酸(PLA)是一种新兴的可生物降解材料,PLA纤维具有良好的透气性和可生物降解性,其单体可通过从农产品发酵获取,工业化制备容易,且具有优良的可生物降解能力和机械性能,在无纺布材料领域具有很好的发展前景。为拓宽PLA无纺布在医疗等中高端行业的应用,在使用中减少细菌污染以及延长可降解材料的保质期,需赋予PLA无纺布更好的抗菌性能。
鉴于此,本研究采用自由基捕捉反应和扩链反应弥补降解作用的策略,采用抗氧化剂和扩链剂提高了PLA/氧化锌(ZnO)切片的热力学性能和连续可纺性,成功连续制备了可生物降解PLA/ZnO/助剂抗菌切片、无纺布和纤维(图1)。

(a)PLA/ZnO/助剂切片 (b)PLA/ZnO/助剂无纺布
(c)PLA/ZnO/助剂纤维(牵伸后) (d)PLA/ZnO/助剂纤维(牵伸前)
图1 可生物降解PLA/ZnO/助剂抗菌切片,无纺布和纤维
所开发的无纺布对大肠杆菌和金黄色葡萄球菌具有优良的抗菌性能,当ZnO含量为1.5 wt%时,对大肠杆菌和金黄色葡萄球菌的抑菌率分别为98.52 %,98.13 %(图2、图3)。

(a)PLA (b)PLA/ZnO-0.5/1010-1/ADR-1 (c)PLA/ZnO-1/1010-2/ADR-2
(d)PLA/ZnO-1.5/1010-3/ADR-3 (e)PLA/ZnO-2/1010-4/ADR-4
图2 可生物降解PLA/ZnO/助剂无纺布对大肠杆菌的抗菌性
(a)PLA (b)PLA/ZnO-0.5/1010-1/ADR-1 (c)PLA/ZnO-1/1010-2/ADR-2
(d)PLA/ZnO-1.5/1010-3/ADR-3 (e)PLA/ZnO-2/1010-4/ADR-4
图3 可生物降解PLA/ZnO/助剂无纺布对金黄色葡萄球菌的抗菌性
进一步阐明了PLA/ZnO/助剂无纺布的抗菌作用机制:首先,细菌整体带负电,而从ZnO中溶解出来的锌离子带正电,两者相互吸引。最终,锌离子附着在细菌表面,穿透细胞膜,导致蛋白质变性和细胞死亡。ZnO本身和细菌接触也会导致细菌细胞膜的破裂和死亡。其次,在光照射下,纳米ZnO的电子可以通过吸收足够的光能从价带(VB)移动到导带(CB),从而在VB中形成带正电的空穴(h+),在CB中形成自由电子(e-)。电子和空穴分别具有很强的还原和氧化能力。它们能与介质中的物质(如H2O和O2)发生反应,产生•O2-1和•OH,并能进入细胞,与多种蛋白质或酶发生反应。这阻碍了细胞的正常生理功能,导致细胞死亡,如图4所示。

图4 可生物降解抗菌PLA/ZnO/助剂无纺布作用机制
本研究成功开发了具有优良热稳定性和抗菌性能的可生物降解无纺布和纤维,具有产业化的潜力,借助海南确定为自由自贸港、国家生态文明试验区和《禁塑方案》的发布,有望在医用口罩、防护服和医用敷料等领域应用和推广。
杏吧原创
硕士张睿为论文第一作者,杏吧原创
潘莉莎教授为论文通讯作者。本研究得到了国家自然科学基金(222668017)的资助。
论文链接://doi.org/10.1016/j.ijbiomac.2024.132188
撰稿人:潘莉莎
审核人:潘福生
窗体底端
窗体底端

